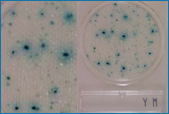
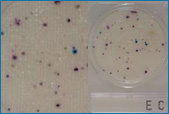
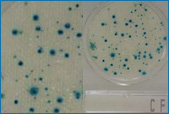
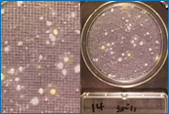
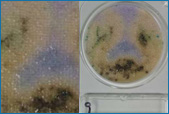
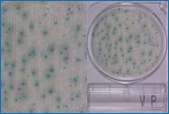
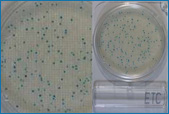

|
|
|
Microbiological analysis optimization of FOOD. |
New microbiological analysis methods successfully used in leading laboratories |
|
CONTENTS
|
|
Global trend in the use of chromogenic medias:
- MUGPLUS Cfs.Agar
- TBX Agar
- MCC Broth
- CHROMOSALM Agar
- CHROMOCYTOGENES Ottaviani & Agosti Agar
- PCA-Chromogenic
- PCA-MILK Chromogenic
|
|
|
|
Other medias of extraordinary interest for food use:
- Buff. Peptone Neutralizing Purple versus classic Buffered peptone water.
- Rose Bengal Caf. Agar versus Sabouraud/YGC Agar.
- SS Broth versus Rappaport VS Broth.
- MKT parahaemolyticus Broth versus Alkaline Saline Broth.
|
|
200 other medias in 500g or 100g bottles (less possibilities for humidity, lasts longer in optimum condition) for ALL the ISO standards, ALL parameters, and ALL food matrixes (please see the table for the most recommendable medias according to the matrixes and parameters in the catalogue). Formula manufacturing (confidential or otherwise) by order. If you can’t find what you need, we will manufacture it for you. |
|
|
|
Microbiological analysis optimization of FOOD.
Compact-Dry-Plates ® Range
The revolution of en masse culture without the need to melt medias!
|
|
 |
|
|
|
|
Total aerobic |
|
Yeasts and moulds |
|
Coliforms and E.coli |
 |
 |
|
|
|
|
Enterobacteria |
|
Coliforms |
|
Staphylococcus aureus |
|
|
|
|
|
|
Salmonella |
|
Vibrio parahaemolyticus |
|
Enterococcus |
|
|
validated protocol for microbiological analysis of food
42 pages of improvements in microbiological food analysis, known thanks to our intercomparative service.
An example of one of the numerous work diagrams from this protocol:
|
|
SEILALIMENTOS intercomparative service
… All of these are at your disposal |
|